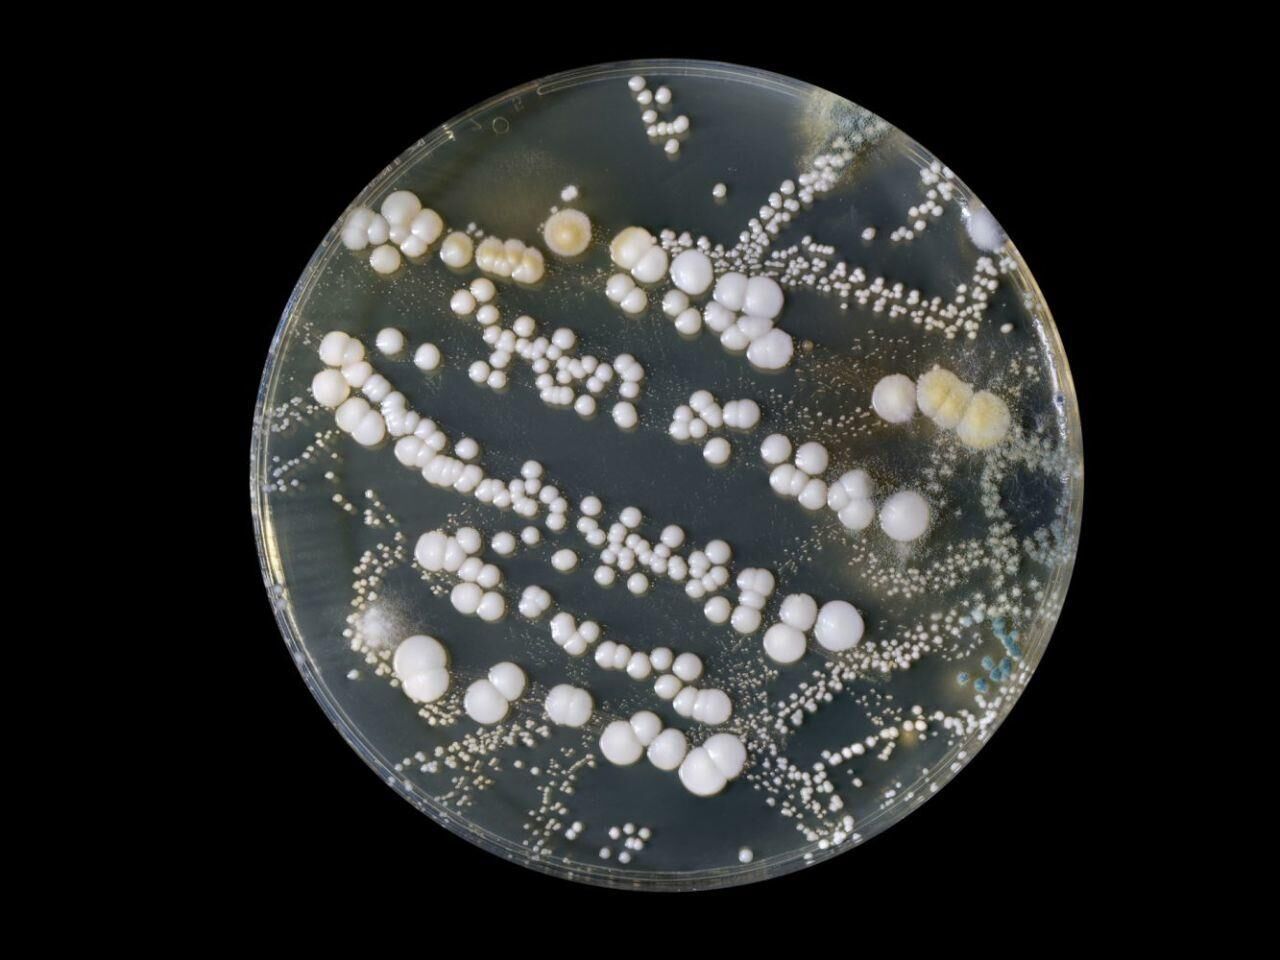
BAKTERİ ÜRETİM DENEY SETİ

BAKTERİ ÜRETİM DENEY SETİ
%26
567,60 TL
420,00 TL
44,10 TL den başlayan taksitlerle!!
Stok Kodu
F1321
Stok Durumu
Stokta Var
Marka
Garanti Süresi
24 Ay
Tahmini Kargoya Teslim: 3 gün içinde
BAKTERİ BÜYÜTME DENEY SETİ
Ürün Kodu: F1321
Ürün Tipi: Deney Seti
Ürün Açıklaması:
BAKTERİ BÜYÜTME DENEY SETİ
Bakteri tek hücreli mikroorganizma grubudur. Tipik olarak birkaç mikrometre uzunluğunda olan bakterilerin çeşitli şekilleri vardır, kimi küresel, kimi spiral şekilli, kimi çubuksu, kimi virgül şeklinde olabilir. Yeryüzündeki her ortamda bakteriler mevcuttur. Toprakta, deniz suyunda, okyanusun derinliklerinde, yer kabuğunda, deride, hayvanların bağırsaklarında, asitli sıcak su kaynaklarında, radyoaktif atıklarda büyüyebilen tipleri vardır. Tipik olarak bir gram toprakta bulunan bakteri hücrelerinin sayısı 40 milyon, bir mililitre tatlı suda ise bir milyondur; toplu olarak dünyada beş nonilyon (5×1030) bakteri bulunmaktadır, bunlar dünyadan biyokütleninçoğunu oluşturur. Bakteriler gıdaların geri dönüşümü için hayati bir öneme sahiptirler ve gıda döngülerindeki çoğu önemli adım, atmosferden azot fiksasyonu gibi, bakterilere bağlıdır. Ancak bu bakterilerin çoğu henüz tanımlanmamıştır ve bakteri şubelerinin sadece yaklaşık yarısı laboratuvarda kültürlenebilen türlere sahiptir. Bakterilerin araştırıldığı bilim bakteriyolojidir, bu, mikrobiyolojinin bir dalıdır.
Bu deney seti ile insan elinin değdiği her yerde ne kadar çok bakteri olduğunu , ne kadar dikkatli olmamız gerektiğini göreceğiz. Set ile birlikte kolay bir şekilde bakteri yetiştirebileceğimizi göreceğiz.
Ürün Tipi: Deney Seti
Ürün Açıklaması:
BAKTERİ BÜYÜTME DENEY SETİ
Bakteri tek hücreli mikroorganizma grubudur. Tipik olarak birkaç mikrometre uzunluğunda olan bakterilerin çeşitli şekilleri vardır, kimi küresel, kimi spiral şekilli, kimi çubuksu, kimi virgül şeklinde olabilir. Yeryüzündeki her ortamda bakteriler mevcuttur. Toprakta, deniz suyunda, okyanusun derinliklerinde, yer kabuğunda, deride, hayvanların bağırsaklarında, asitli sıcak su kaynaklarında, radyoaktif atıklarda büyüyebilen tipleri vardır. Tipik olarak bir gram toprakta bulunan bakteri hücrelerinin sayısı 40 milyon, bir mililitre tatlı suda ise bir milyondur; toplu olarak dünyada beş nonilyon (5×1030) bakteri bulunmaktadır, bunlar dünyadan biyokütleninçoğunu oluşturur. Bakteriler gıdaların geri dönüşümü için hayati bir öneme sahiptirler ve gıda döngülerindeki çoğu önemli adım, atmosferden azot fiksasyonu gibi, bakterilere bağlıdır. Ancak bu bakterilerin çoğu henüz tanımlanmamıştır ve bakteri şubelerinin sadece yaklaşık yarısı laboratuvarda kültürlenebilen türlere sahiptir. Bakterilerin araştırıldığı bilim bakteriyolojidir, bu, mikrobiyolojinin bir dalıdır.
Bu deney seti ile insan elinin değdiği her yerde ne kadar çok bakteri olduğunu , ne kadar dikkatli olmamız gerektiğini göreceğiz. Set ile birlikte kolay bir şekilde bakteri yetiştirebileceğimizi göreceğiz.
DENEY SETİ İÇERİĞİ;
Ürün Adı
Agar Agar 25Gr.
Pamuklu Çubuk 1 Adet
Petri Kabı 1 Adet
Kilitli Poşet 1 Adet
Etiket 100'lü Paket
Ürün Adı
Agar Agar 25Gr.
Pamuklu Çubuk 1 Adet
Petri Kabı 1 Adet
Kilitli Poşet 1 Adet
Etiket 100'lü Paket
Bu ürüne ilk yorumu siz yapın!
Garanti Koşulları
Tüm ürünler aksi belirtilmedikçe üretici garantisi kapsamındadır. Garanti koşullarının geçerli olduğundan emin olmak için teslimat sırasında ürünü kontrol etmeniz gerekmektedir. Hasar gördüğünüzde not alın ve ürünü kargo görevlisinden teslim almayın. Üründe yapılan değişiklikler, ürünün deformasyonu veya ürünün orijinal tasarımının bozulması garanti kapsamı dışındadır.
Ürün İade Politikası
Web sitemizden satın aldığınız bir ürünün kusurlu olduğu tespit edilirse, teslimat tarihinden itibaren en geç 3 gün içinde sayfamızdaki online destek bölümünden bizimle iletişime geçmeniz gerekmektedir. Bu bilgilere istinaden kargo şirketi aracılığıyla bize göndereceğiniz ayıplı ürün yenisi ile değiştirilecektir. Sipariş edilen ürün müşteri kullanımından dolayı kusurlu ise veya ürün 3 gün içerisinde kullanılmış ise iade ve değişim yapılmamaktadır. Ürün iade ve değişim şartı olarak 4077 sayılı Tüketicinin Korunması Hakkında Kanun'a uyulması esastır.